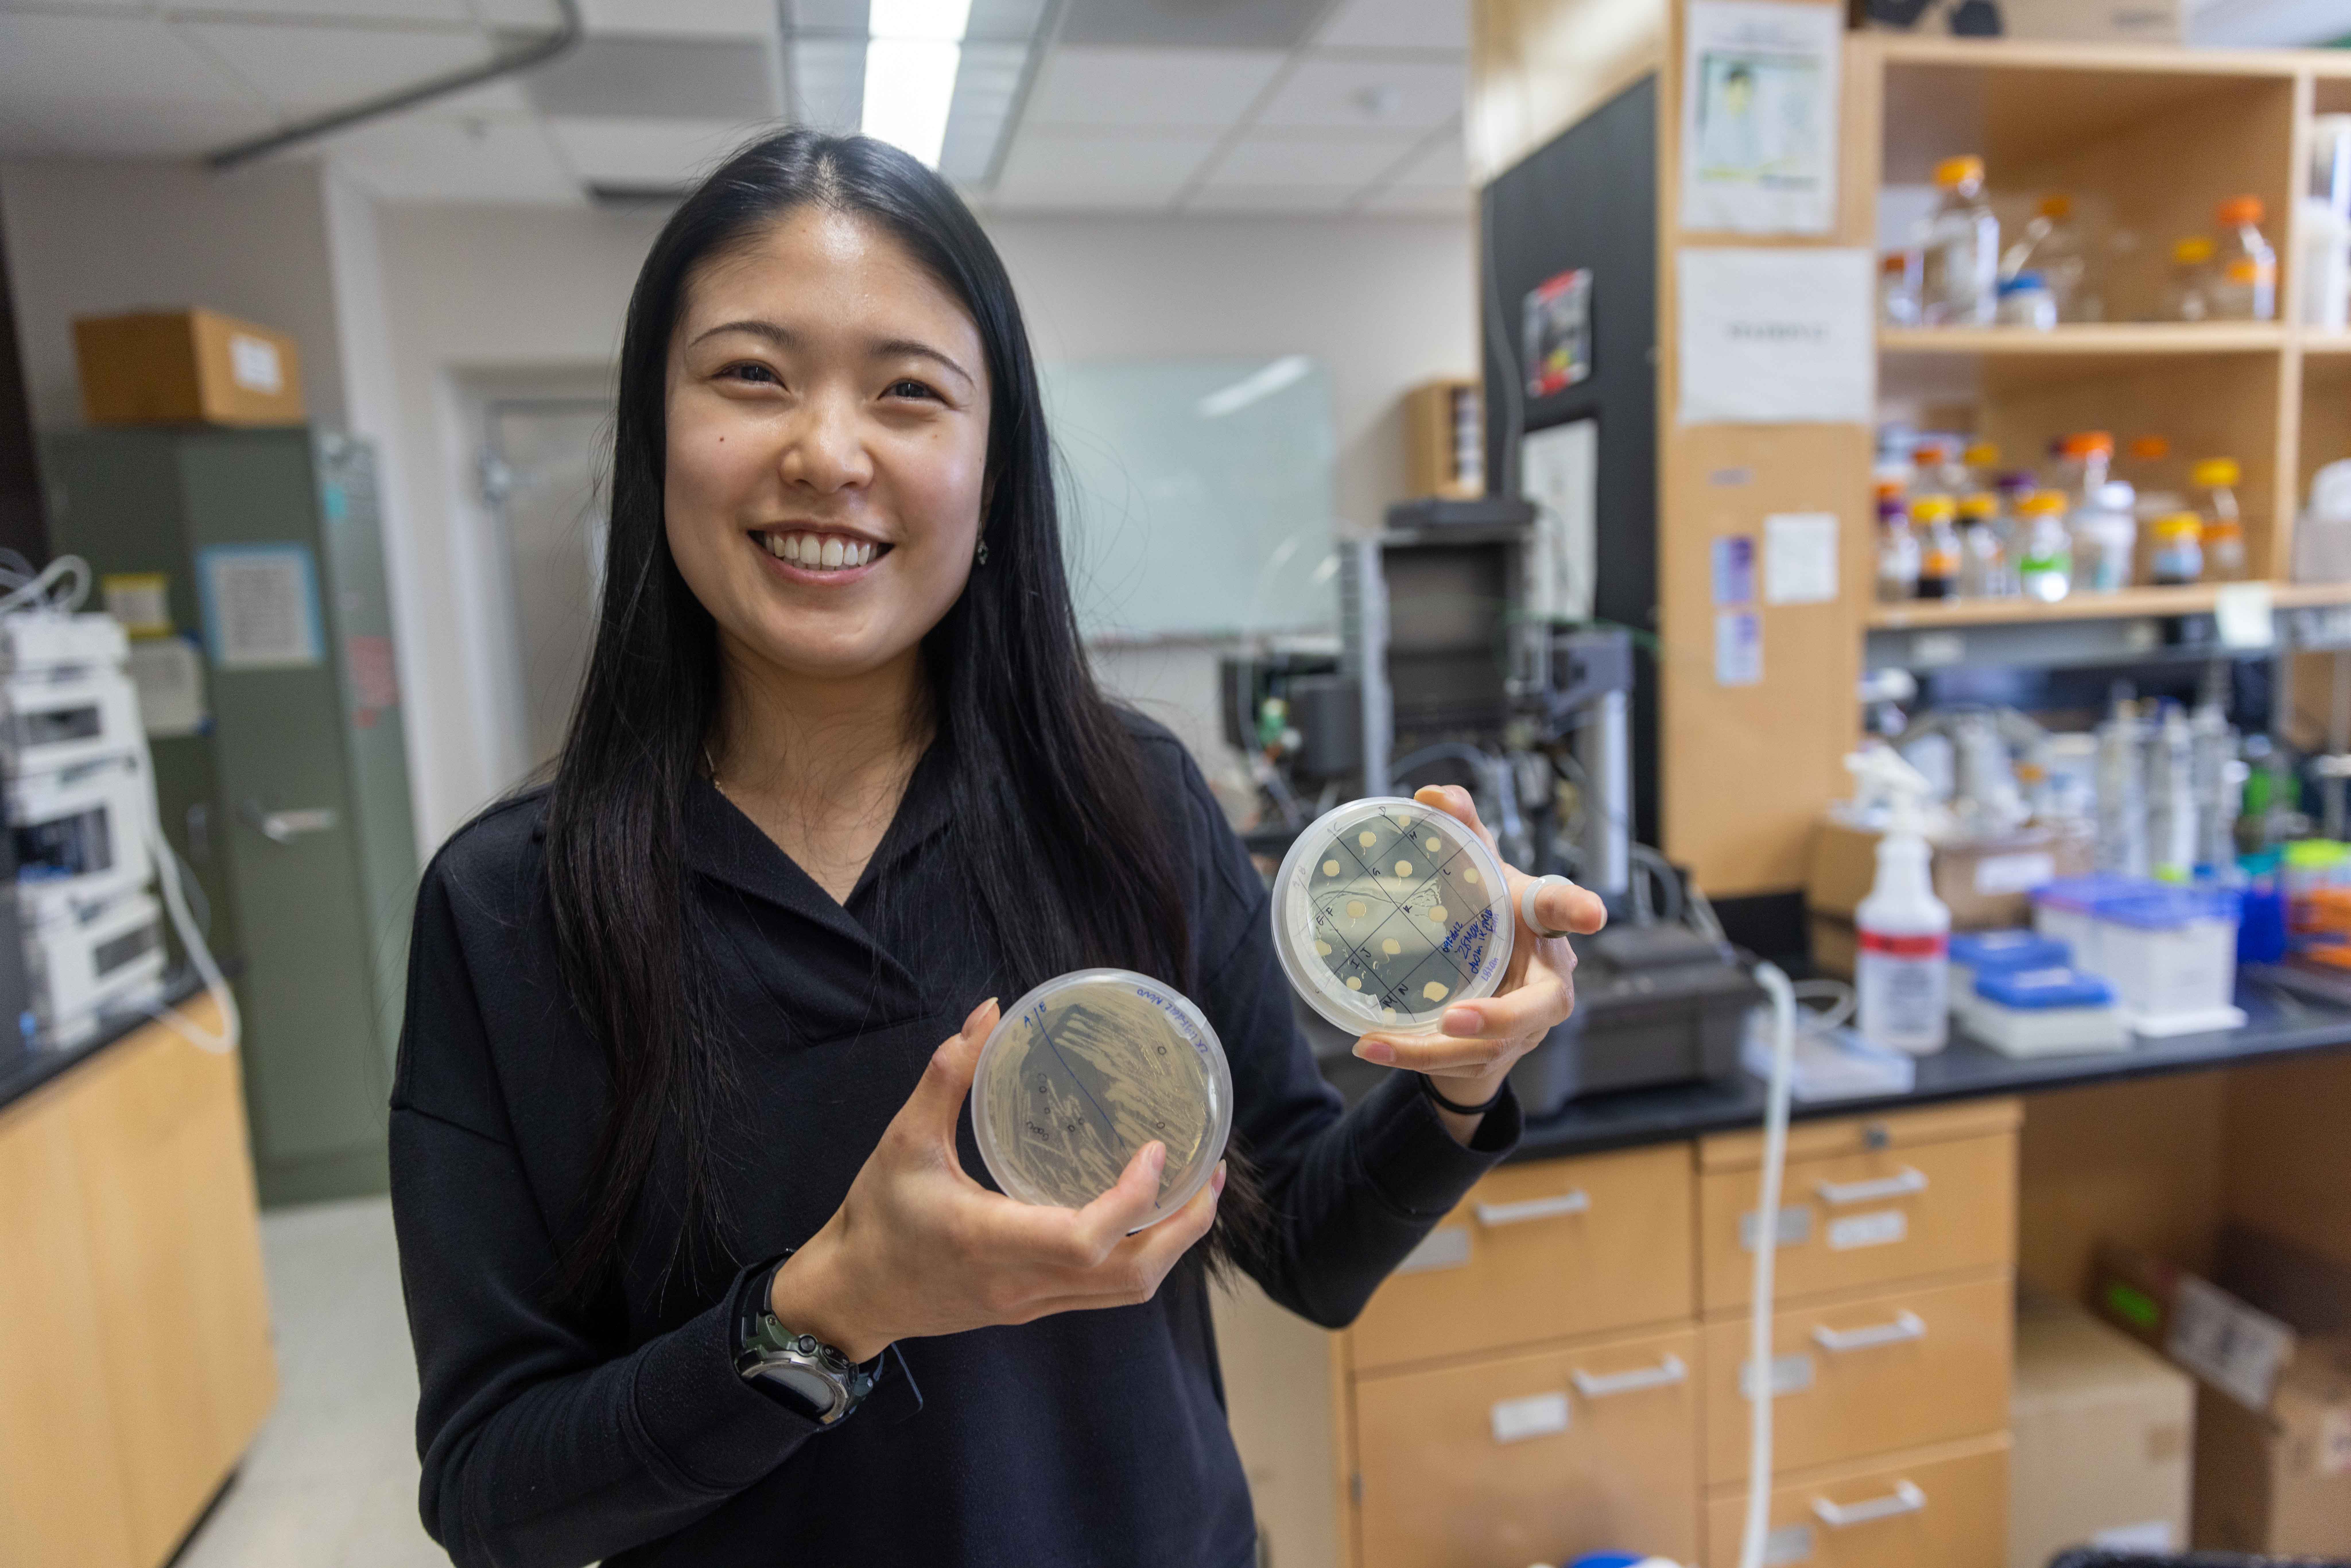
woman with long black hair standing in a lab holding two petri dishes

Grad Student Spotlight: Fong Liew
Fong Liew is a graduate student in Brian Fox’s biochemistry lab, where she works in collaboration with Tim Donohue’s bacteriology lab on converting lignin, one of the main components of plant cell walls, into valuable industrial chemicals.
Tell me about your research. How are you collaborating with the Donohue lab?
The Donohue lab has a strain of Novosphingum aromaticivorans that is capable of funneling various lignin degradation intermediates into a single platform molecule, PDC. While there are growing potential uses for PDC, it currently lacks an industrial market ready for its consumption. To address this, my project focuses on converting PDC into adipic acid, which is a high-volume commodity chemical used as a precursor to nylon. I will be achieving that goal by finding or designing enzymes that are capable of that conversion. The main challenge of this project is converting the seven-carbon PDC into a six-carbon adipic acid precursor. The challenge with that project is that PDC is a seven-carbon molecule, whereas adipic acid is a six-carbon molecule. So in the process, we have to lose a carbon. I found within N. aromaticivorans, there are some enzymes that are capable of opening the carbon ring of PDC. And then we have tested some yeast enzymes that are capable of taking off a carbon once the ring is open. Through my work, I have found that this conversion can be achieved with a combination of native and yeast-derived enzymes.
How did you get involved with your current project?
The researcher I worked with in undergrad studied metalloproteins [proteins, such as hemoglobin, that contain metals and are vital for biological functions including oxygen transport and photosynthesis] and I worked on characterizing a heme enzyme. I really enjoyed what I did, but when I first joined grad school, I wanted to try something different, so I rotated in very different labs. From those rotations, I realized my favorite thing is probably still figuring out the biochemistry of enzymes.

What about metalloproteins appeals to you?
I really enjoy working with proteins and biochemistry. When I think of science, I categorize them into physics, chemistry and biology. Biology, in my opinion, can be very unpredictable. You have a lot of exceptions in biology. In chemistry, a lot of things are more predictable, and so is physics. I like the in-between of biochemistry. It's still somewhat predictable, because there are all the different properties of the amino acids that you can kind of predict. But at the same time, it is still a biological thing, so it can surprise you at times. The unexpected things make it interesting.
I like metalloproteins because most metalloproteins have colors. Most other proteins will be colorless. As you're purifying it, you have to use the UV to actually see if you got your protein or not. But with metalloproteins, you can see the (color) bands coming out and the different redox state of the metal can cause the color to change! So I find it really fun.
What do you enjoy about your research?
Part of my research that makes me more invested is I feel that even if it doesn’t contribute a lot, this might be a very tiny step to making the world a little bit more sustainable. Just like adding more information, how can we make plastic in a more sustainable way? It may never become a thing, but at least I like to think that I have somehow contributed a little bit. I also enjoy how collaborative my project is. It allows me to work with people from many different labs, so I learn a lot from them.
At what point did you realize you wanted to do research? What made you interested in science?
It was in my undergrad [at the University of Washington]. I was originally pre-med, but then I joined an undergrad lab for my capstone project. I found that there was a lot of freedom to explore. It’s the right balance of problem solving and troubleshooting. And when the experiment works, it's pretty exciting. So I like that part of it. After that, I went to shadow doctors and volunteered at hospitals and I did not enjoy doing that as much.

So the actual doing of it that for you made you realize “this is what I want?”
I wanted to do research before, but I also was not exposed to it. That wasn't an option that I had known I could do until I did it.
What do you like about working at the GLBRC?
I think WEI has a lot of resources that I can leverage. I use the mass spectrometer here a lot, and there are a lot of people who are very knowledgeable in their field that I can ask questions to. People like Craig Bingman, Steve Karlen, and Avery Vilbert — they're all super smart people that I get to work with and learn from. There are also a lot of resources for me as I look into my future. I go to Alex [Schnoes] with questions and ask her to look at my resume and things like that. I am also part of the mentorship program now with Yiying as my mentor and that has been really insightful for me.
What are you interested in doing in the future?
I am currently looking into life science consulting, project management or product management type roles. I would still like to do something related to science but off the bench. I also enjoy talking and connecting different people, so I think a role that requires a lot of liaising and collaboration would be something that interests me.
Outside of work what do you like to do?
My two main interests are being outdoors and food. I really like hiking, skiing; anything outdoors. Being in Wisconsin, I've been picking up some water spots too and ice skating. I run quite a lot sometimes, it helps me de-stress. I also like making food and trying different food from different cultures. I love Vietnamese cuisine. I'm very biased, because I'm from Singapore, but my top two favorite cuisines would be Vietnamese and Singaporean.